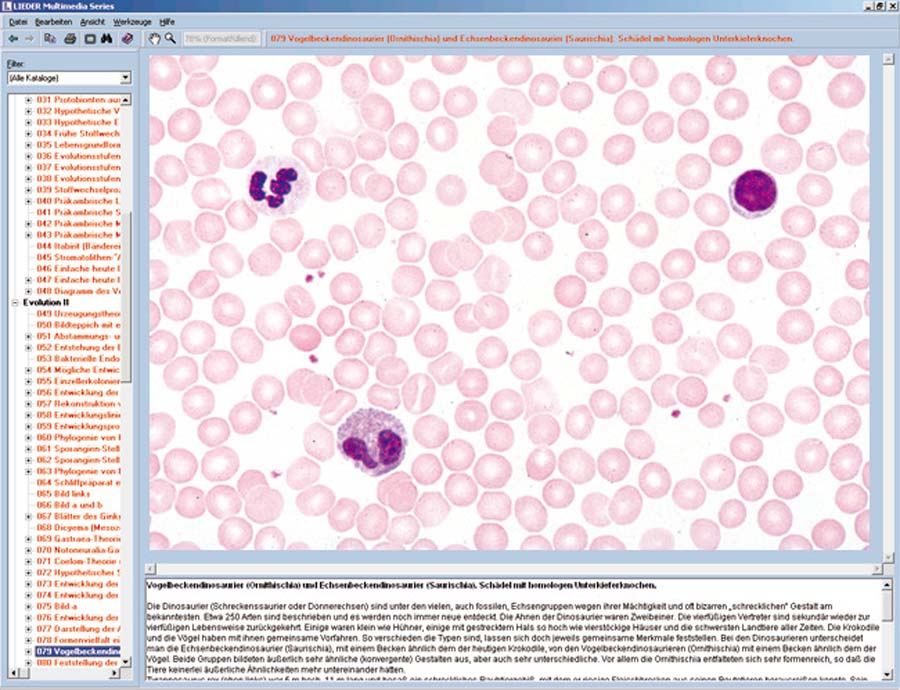

Biologie

Passend zu den Themen und Lerninhalten der Multimediapakete für Lehrer und Schüler enthalten die CD eine große Anzahl weiterer Bilder und Texte. Neuartiges virtuelles Mikroskop mit verschiedenen Vergrößerungsstufen, Test- und Demoprogramme.Alle Bilder und Texte können gedruckt werden. Die CD-ROM kann jeweils getrennt oder mit den Multimediapaket zusammen bestellt werden.Basis CD Erlaeuterung-Multimedia-Pakete-CD-ROM.pdf

Passend zu den Themen und Lerninhalten der Multimediapakete für Lehrer und Schüler enthalten die CD eine große Anzahl weiterer Bilder und Texte. Neuartiges virtuelles Mikroskop mit verschiedenen Vergrößerungsstufen, Test- und Demoprogramme.Alle Bilder und Texte können gedruckt werden. Die CD-ROM kann jeweils getrennt oder mit den Multimediapaket zusammen bestellt werden.Basis CD Erlaeuterung-Multimedia-Pakete-CD-ROM.pdf

Passend zu den Themen und Lerninhalten der Multimediapakete für Lehrer und Schüler enthalten die CD eine große Anzahl weiterer Bilder und Texte. Neuartiges virtuelles Mikroskop mit verschiedenen Vergrößerungsstufen, Test- und Demoprogramme.Alle Bilder und Texte können gedruckt werden. Die CD-ROM kann jeweils getrennt oder mit den Multimediapaket zusammen bestellt werden.Ergänzungs CD Erlaeuterung-Multimedia-Pakete-CD-ROM.pdf

Passend zu den Themen und Lerninhalten der Multimediapakete für Lehrer und Schüler enthalten die CD eine große Anzahl weiterer Bilder und Texte. Neuartiges virtuelles Mikroskop mit verschiedenen Vergrößerungsstufen, Test- und Demoprogramme.Alle Bilder und Texte können gedruckt werden. Die CD-ROM kann jeweils getrennt oder mit den Multimediapaket zusammen bestellt werden.Basis CD Erlaeuterung-Multimedia-Pakete-CD-ROM.pdf

Passend zu den Themen und Lerninhalten der Multimediapakete für Lehrer und Schüler enthalten die CD eine große Anzahl weiterer Bilder und Texte. Neuartiges virtuelles Mikroskop mit verschiedenen Vergrößerungsstufen, Test- und Demoprogramme.Alle Bilder und Texte können gedruckt werden. Die CD-ROM kann jeweils getrennt oder mit den Multimediapaket zusammen bestellt werden.Basis CD Erlaeuterung-Multimedia-Pakete-CD-ROM.pdf

Passend zu den Themen und Lerninhalten der Multimediapakete für Lehrer und Schüler enthalten die CD eine große Anzahl weiterer Bilder und Texte. Neuartiges virtuelles Mikroskop mit verschiedenen Vergrößerungsstufen, Test- und Demoprogramme.Alle Bilder und Texte können gedruckt werden. Die CD-ROM kann jeweils getrennt oder mit den Multimediapaket zusammen bestellt werden.Basis CD Erlaeuterung-Multimedia-Pakete-CD-ROM.pdf

Passend zu den Themen und Lerninhalten der Multimediapakete für Lehrer und Schüler enthalten die CD eine große Anzahl weiterer Bilder und Texte. Neuartiges virtuelles Mikroskop mit verschiedenen Vergrößerungsstufen, Test- und Demoprogramme.Alle Bilder und Texte können gedruckt werden. Die CD-ROM kann jeweils getrennt oder mit den Multimediapaket zusammen bestellt werden.Basis CD Erlaeuterung-Multimedia-Pakete-CD-ROM.pdf

Passend zu den Themen und Lerninhalten der Multimediapakete für Lehrer und Schüler enthalten die CD eine große Anzahl weiterer Bilder und Texte. Neuartiges virtuelles Mikroskop mit verschiedenen Vergrößerungsstufen, Test- und Demoprogramme.Alle Bilder und Texte können gedruckt werden. Die CD-ROM kann jeweils getrennt oder mit den Multimediapaket zusammen bestellt werden.Ergänzungs CD Erlaeuterung-Multimedia-Pakete-CD-ROM.pdf

Passend zu den Themen und Lerninhalten der Multimediapakete für Lehrer und Schüler enthalten die CD eine große Anzahl weiterer Bilder und Texte. Neuartiges virtuelles Mikroskop mit verschiedenen Vergrößerungsstufen, Test- und Demoprogramme.Alle Bilder und Texte können gedruckt werden. Die CD-ROM kann jeweils getrennt oder mit den Multimediapaket zusammen bestellt werden.Basis CD Erlaeuterung-Multimedia-Pakete-CD-ROM.pdf

Passend zu den Themen und Lerninhalten der Multimediapakete für Lehrer und Schüler enthalten die CD eine große Anzahl weiterer Bilder und Texte. Neuartiges virtuelles Mikroskop mit verschiedenen Vergrößerungsstufen, Test- und Demoprogramme.Alle Bilder und Texte können gedruckt werden. Die CD-ROM kann jeweils getrennt oder mit den Multimediapaket zusammen bestellt werden.Basis CD Erlaeuterung-Multimedia-Pakete-CD-ROM.pdf

Passend zu den Themen und Lerninhalten der Multimediapakete für Lehrer und Schüler enthalten die CD eine große Anzahl weiterer Bilder und Texte. Neuartiges virtuelles Mikroskop mit verschiedenen Vergrößerungsstufen, Test- und Demoprogramme.Alle Bilder und Texte können gedruckt werden. Die CD-ROM kann jeweils getrennt oder mit den Multimediapaket zusammen bestellt werden.Ergänzungs CD Erlaeuterung-Multimedia-Pakete-CD-ROM.pdf

Passend zu den Themen und Lerninhalten der Multimediapakete für Lehrer und Schüler enthalten die CD eine große Anzahl weiterer Bilder und Texte. Neuartiges virtuelles Mikroskop mit verschiedenen Vergrößerungsstufen, Test- und Demoprogramme.Alle Bilder und Texte können gedruckt werden. Die CD-ROM kann jeweils getrennt oder mit den Multimediapaket zusammen bestellt werden.Basis CD Erlaeuterung-Multimedia-Pakete-CD-ROM.pdf

Die CD bringt im ersten Teil außerordentlich instruktives morphologisches und anatomisches Bildmaterial, das die Entwicklung und Abstammung im Tierreich verdeutlicht. Dabei handelt es sich um drei bezeichnende Grunderscheinungen des Entwicklungsgeschehens: Stufenreihen aufsteigender Organisationshöhe, Gemeinsamkeit des Grundbauplanes und rudimentäre Organe.Seit den Arbeiten von Charles Darwin sind Untersuchungen der Artbildung auf isolierten vulkanischen Inselgruppen zu Musterbeispielen der Evolutionsforschung geworden. Die Fauna isolierter Lebensräume, wie der Galápagos-Inseln, spielt als Lieferant indirekter Beweise eine besonders wichtige Rolle für die Evolutionslehre. Das Zusammenwirken von Isolation, Selektion, Einnischung, Gendrift und Mutation kann in höchst anschaulicher Weise beobachtet werden. Am Beispiel der einzigartigen Flora der Kanaren werden evolutionäres Geschehen durch Gründereffekte, die Bewahrung von Paläoendemiten, die Wirkung von Separation und Isolation, die Artenbildung durch adaptive Radiation, Vorgänge der Selektion und Annidation, Analogie und Homologie modellhaft aufgezeigt. Die Kanarischen Inseln sind daher wie die Galapagos-Inseln oder die Hawaii-Gruppe ein Museum der Evolution.Interaktive Lehr- und Lernmedien auf CD-ROM Erlaeuterung-Interaktive CD-ROM.pdf

Wer den Bauplan eines Tieres verstehen will, muß die Entwicklung vom Ei bis zum fertigen Tier kennen. Die CD zeigt die Stadien der Ontogenese an den klassischen Beispielen von Seeigel, Frosch und Huhn und dokumentiert die Entwicklung dieser repräsentativen Tiere vom Ei über die Furchungsteilungen, die Entwicklung der Keimblätter bis zum fertigen Organismus. Knappe, klare Texte und erläuternde Skizzen ermöglichen es dem Benutzer, rasch ein Bild vom Ablauf der Keimesentwicklung zu gewinnen.Interaktive Lehr- und Lernmedien auf CD-ROM

Grundbestandteil des Systems sind die vier Mikropräparate-Schulserien A, B, C und D. Die Serien sind systematisch geordnet und so zusammengestellt, dass eine auf der anderen aufbaut und eine Erweiterung des Stoffgebietes der vorhergehenden bringt. Jedes einzelne Präparat ist sorgfältig ausgewählt und auf seinen Lehrwert hin überprüft worden. Bei der Auswahl der Präparate wurde solchen der Vorzug gegeben, die für die entsprechende Tier- oder Pflanzengruppe typisch sind.Das Material ist reichlich bemessen, so dass der Lehrer auswählen und variieren kann.Die Mikropräparate werden in unseren Laboratorien unter wissenschaftlicher Leitung hergestellt. Sie sind das Ergebnis jahrzehntelanger Erfahrung auf allen Gebieten der Präparationstechnik. Die Herstellung der Mikrotomschnitte erfolgt durch erfahrene Fachkräfte, Schneidetechnik und Schnittdicke werden den Objekten angepaßt.Aus der großen Zahl der in der Mikroskopie üblichen Färbemethoden wählen wir solche, die eine klare und kontrastreiche Darstellung der gewünschten Strukturen mit bester Haltbarkeit verbinden.Meist handelt es sich dabei um aufwendige Mehrfachfärbungen. Die Mikropräparate werden auf feinbekanteten Objektträgern im Format 26 x 76 mm geliefert. Jedes Mikropräparat ist ein Unikat. Wir möchten deshalb darauf hinweisen, dass gelieferte Präparate von den Abbildungen in diesem Katalog abweichen können, bedingt durch natürliche Variation der Ausgangsmaterialien und der angewandten Präparations- und Färbemethoden.Die Anzahl der vorhandenen Präparateserien, oder zumindest von Teilen daraus, sollte in etwa der Zahl der vorhandenen Mikroskope entsprechen, so dass mehrere Schüler gleichzeitig die gleichen Präparate untersuchen können. Alle Mikropräparate aus der Serie können auch einzeln bezogen werden.(Bitte Anfragen).WICHTIG gleich mitbestellen:Mikroskopische Präparate können aus technischen Gründen nur in speziellen Präparatekästen versandt werden.Diese liegen in verschiedenen Ausführungen vor und müssen bei Auftragserteilung mitbestellt werden. Falls vom Besteller keine näheren Angaben gemacht werden, liefern wir zu unseren Präparateserien und zu Einzelpräparaten Aufbewahrungskästen unserer Standardausführung in passender Größe. 50 Präparate Schulserie B.pdf

Grundbestandteil des Systems sind die vier Mikropräparate-Schulserien A, B, C und D. Die Serien sind systematisch geordnet und so zusammengestellt, dass eine auf der anderen aufbaut und eine Erweiterung des Stoffgebietes der vorhergehenden bringt. Jedes einzelne Präparat ist sorgfältig ausgewählt und auf seinen Lehrwert hin überprüft worden. Bei der Auswahl der Präparate wurde solchen der Vorzug gegeben, die für die entsprechende Tier- oder Pflanzengruppe typisch sind.Das Material ist reichlich bemessen, so dass der Lehrer auswählen und variieren kann.Die Mikropräparate werden in unseren Laboratorien unter wissenschaftlicher Leitung hergestellt. Sie sind das Ergebnis jahrzehntelanger Erfahrung auf allen Gebieten der Präparationstechnik. Die Herstellung der Mikrotomschnitte erfolgt durch erfahrene Fachkräfte, Schneidetechnik und Schnittdicke werden den Objekten angepaßt.Aus der großen Zahl der in der Mikroskopie üblichen Färbemethoden wählen wir solche, die eine klare und kontrastreiche Darstellung der gewünschten Strukturen mit bester Haltbarkeit verbinden.Meist handelt es sich dabei um aufwendige Mehrfachfärbungen. Die Mikropräparate werden auf feinbekanteten Objektträgern im Format 26 x 76 mm geliefert. Jedes Mikropräparat ist ein Unikat. Wir möchten deshalb darauf hinweisen, dass gelieferte Präparate von den Abbildungen in diesem Katalog abweichen können, bedingt durch natürliche Variation der Ausgangsmaterialien und der angewandten Präparations- und Färbemethoden.Die Anzahl der vorhandenen Präparateserien, oder zumindest von Teilen daraus, sollte in etwa der Zahl der vorhandenen Mikroskope entsprechen, so dass mehrere Schüler gleichzeitig die gleichen Präparate untersuchen können. Alle Mikropräparate aus der Serie können auch einzeln bezogen werden.(Bitte Anfragen).WICHTIG gleich mitbestellen:Mikroskopische Präparate können aus technischen Gründen nur in speziellen Präparatekästen versandt werden.Diese liegen in verschiedenen Ausführungen vor und müssen bei Auftragserteilung mitbestellt werden. Falls vom Besteller keine näheren Angaben gemacht werden, liefern wir zu unseren Präparateserien und zu Einzelpräparaten Aufbewahrungskästen unserer Standardausführung in passender Größe. 50 Präparate Schulserie C.pdf

Grundbestandteil des Systems sind die vier Mikropräparate-Schulserien A, B, C und D. Die Serien sind systematisch geordnet und so zusammengestellt, dass eine auf der anderen aufbaut und eine Erweiterung des Stoffgebietes der vorhergehenden bringt. Jedes einzelne Präparat ist sorgfältig ausgewählt und auf seinen Lehrwert hin überprüft worden. Bei der Auswahl der Präparate wurde solchen der Vorzug gegeben, die für die entsprechende Tier- oder Pflanzengruppe typisch sind.Das Material ist reichlich bemessen, so dass der Lehrer auswählen und variieren kann.Die Mikropräparate werden in unseren Laboratorien unter wissenschaftlicher Leitung hergestellt. Sie sind das Ergebnis jahrzehntelanger Erfahrung auf allen Gebieten der Präparationstechnik. Die Herstellung der Mikrotomschnitte erfolgt durch erfahrene Fachkräfte, Schneidetechnik und Schnittdicke werden den Objekten angepaßt.Aus der großen Zahl der in der Mikroskopie üblichen Färbemethoden wählen wir solche, die eine klare und kontrastreiche Darstellung der gewünschten Strukturen mit bester Haltbarkeit verbinden.Meist handelt es sich dabei um aufwendige Mehrfachfärbungen. Die Mikropräparate werden auf feinbekanteten Objektträgern im Format 26 x 76 mm geliefert. Jedes Mikropräparat ist ein Unikat. Wir möchten deshalb darauf hinweisen, dass gelieferte Präparate von den Abbildungen in diesem Katalog abweichen können, bedingt durch natürliche Variation der Ausgangsmaterialien und der angewandten Präparations- und Färbemethoden.Die Anzahl der vorhandenen Präparateserien, oder zumindest von Teilen daraus, sollte in etwa der Zahl der vorhandenen Mikroskope entsprechen, so dass mehrere Schüler gleichzeitig die gleichen Präparate untersuchen können. Alle Mikropräparate aus der Serie können auch einzeln bezogen werden.(Bitte Anfragen).WICHTIG gleich mitbestellen:Mikroskopische Präparate können aus technischen Gründen nur in speziellen Präparatekästen versandt werden.Diese liegen in verschiedenen Ausführungen vor und müssen bei Auftragserteilung mitbestellt werden. Falls vom Besteller keine näheren Angaben gemacht werden, liefern wir zu unseren Präparateserien und zu Einzelpräparaten Aufbewahrungskästen unserer Standardausführung in passender Größe. 50 Präparate Schulserie D.pdf

Grundbestandteil des Systems sind die vier Mikropräparate-Schulserien A, B, C und D. Die Serien sind systematisch geordnet und so zusammengestellt, dass eine auf der anderen aufbaut und eine Erweiterung des Stoffgebietes der vorhergehenden bringt. Jedes einzelne Präparat ist sorgfältig ausgewählt und auf seinen Lehrwert hin überprüft worden. Bei der Auswahl der Präparate wurde solchen der Vorzug gegeben, die für die entsprechende Tier- oder Pflanzengruppe typisch sind.Das Material ist reichlich bemessen, so dass der Lehrer auswählen und variieren kann.Die Mikropräparate werden in unseren Laboratorien unter wissenschaftlicher Leitung hergestellt. Sie sind das Ergebnis jahrzehntelanger Erfahrung auf allen Gebieten der Präparationstechnik. Die Herstellung der Mikrotomschnitte erfolgt durch erfahrene Fachkräfte, Schneidetechnik und Schnittdicke werden den Objekten angepaßt.Aus der großen Zahl der in der Mikroskopie üblichen Färbemethoden wählen wir solche, die eine klare und kontrastreiche Darstellung der gewünschten Strukturen mit bester Haltbarkeit verbinden.Meist handelt es sich dabei um aufwendige Mehrfachfärbungen. Die Mikropräparate werden auf feinbekanteten Objektträgern im Format 26 x 76 mm geliefert. Jedes Mikropräparat ist ein Unikat. Wir möchten deshalb darauf hinweisen, dass gelieferte Präparate von den Abbildungen in diesem Katalog abweichen können, bedingt durch natürliche Variation der Ausgangsmaterialien und der angewandten Präparations- und Färbemethoden.Die Anzahl der vorhandenen Präparateserien, oder zumindest von Teilen daraus, sollte in etwa der Zahl der vorhandenen Mikroskope entsprechen, so dass mehrere Schüler gleichzeitig die gleichen Präparate untersuchen können. Alle Mikropräparate aus der Serie können auch einzeln bezogen werden.(Bitte Anfragen).WICHTIG gleich mitbestellen:Mikroskopische Präparate können aus technischen Gründen nur in speziellen Präparatekästen versandt werden.Diese liegen in verschiedenen Ausführungen vor und müssen bei Auftragserteilung mitbestellt werden. Falls vom Besteller keine näheren Angaben gemacht werden, liefern wir zu unseren Präparateserien und zu Einzelpräparaten Aufbewahrungskästen unserer Standardausführung in passender Größe. 25 Präparate Schulserie A.pdf
Im Rahmen unseres Multimedia-Programms Mikroskopische Biologie liefern wir interaktive CD, die auf unsere Schulserie A abgestimmt ist. Das Basismaterial bildet hervorragende Mikrofotos aller in der Schulserie enthaltenen Mikropräparate in mehrfachen Vergrößerungsstufen und Bildausschnitten. Darüberhinaus werden eine große Zahl zusätzliche zu den Themen passende Präparate gezeigt, die der Erweiterung der vorhandenen Präparateserie dienen. Anatomische Farbtafeln und schematische Zeichnungen sowie ausführliche Texte zu allen Einzelthemen dienen der Erläuterung der Präparate und können ausgedruckt werden.Mikroaufnahmen, Zeichnungen, Begleitmaterial und Kopiervorlagen

Im Rahmen unseres Multimedia-Programms Mikroskopische Biologie liefern wir interaktive CD, die auf unsere Schulserie B abgestimmt ist. Das Basismaterial bildet hervorragende Mikrofotos aller in der Schulserie enthaltenen Mikropräparate in mehrfachen Vergrößerungsstufen und Bildausschnitten. Darüberhinaus werden eine große Zahl zusätzliche zu den Themen passende Präparate gezeigt, die der Erweiterung der vorhandenen Präparateserie dienen. Anatomische Farbtafeln und schematische Zeichnungen sowie ausführliche Texte zu allen Einzelthemen dienen der Erläuterung der Präparate und können ausgedruckt werden.Mikroaufnahmen, Zeichnungen, Begleitmaterial und Kopiervorlagen

Im Rahmen unseres Multimedia-Programms Mikroskopische Biologie liefern wir interaktive CD, die auf unsere Schulserie C abgestimmt ist. Das Basismaterial bildet hervorragende Mikrofotos aller in der Schulserie enthaltenen Mikropräparate in mehrfachen Vergrößerungsstufen und Bildausschnitten. Darüberhinaus werden eine große Zahl zusätzliche zu den Themen passende Präparate gezeigt, die der Erweiterung der vorhandenen Präparateserie dienen. Anatomische Farbtafeln und schematische Zeichnungen sowie ausführliche Texte zu allen Einzelthemen dienen der Erläuterung der Präparate und können ausgedruckt werden.Mikroaufnahmen, Zeichnungen, Begleitmaterial und Kopiervorlagen

Im Rahmen unseres Multimedia-Programms Mikroskopische Biologie liefern wir interaktive CD, die auf unsere Schulserie D abgestimmt ist. Das Basismaterial bildet hervorragende Mikrofotos aller in der Schulserie enthaltenen Mikropräparate in mehrfachen Vergrößerungsstufen und Bildausschnitten. Darüberhinaus werden eine große Zahl zusätzliche zu den Themen passende Präparate gezeigt, die der Erweiterung der vorhandenen Präparateserie dienen. Anatomische Farbtafeln und schematische Zeichnungen sowie ausführliche Texte zu allen Einzelthemen dienen der Erläuterung der Präparate und können ausgedruckt werden.Mikroaufnahmen, Zeichnungen, Begleitmaterial und Kopiervorlagen

Ein Kind entsteht - Magnetisches Tafelmaterial - anschaulich und sachlich - verständlich erklärt - Begriffe auf Deutsch und Englisch Wie entsteht Leben? Kinder und Jugendliche möchten wissen, wie Leben entsteht. Zeigen Sie an der Tafel nicht nur wie, sondern auch wo menschliches Leben entsteht. Das magnetische Material hilft Ihnen, das Thema unbefangen zu vermitteln. Erklären Sie sachlich Begriffe wie Eileiter, Eisprung, Befruchtung, Zellteilung, Einnistung, Gebärmutter, Scheide, Penis, Hoden, Samenproduktion, Samenzellen usw. Bilingual auf verschiedenem Leistungsniveau Für den bilingualen Unterricht (Englisch/Deutsch) verwenden Sie die Rückseite der beidseitig magnetischen Namensschilder. In der beiliegenden Handreichung finden Sie das Unterrichtsthema schon komplett vorbereitet. Die Kopiervorlagen (Arbeits- und Lösungsblätter) sind in 3 verschiedenen Niveaustufen ausgearbeitet. Dies ermöglicht Ihnen das Arbeiten sowohl mit Grund- als auch mit Sekundarschülern. Lieferumfang Insgesamt 37 Teile: - 21 Magnetbilder - 15 magnetische Namensschilder (deutsch/englisch) - 1 Handreichung mit Kopiervorlagen, DIN A4, 23 Seiten Ein Kind entstehtmagnetisches Tafelmaterial

Mikroskop HPM 210 LED mit LED-Beleuchtung und 4-fach Objektivrevolver. Monokulares Mikroskop mit Metallstativ und koaxialem Grob- und Feintrieb. Vergrößerung (-fach): 1000 (50, 100, 500, 1000) Okular (-fach): 10 (Weitfeld-Okular) Lampentyp: LED Kondensor: Abbe (N.A. 1,25, Spiralkondensor, höhenverstellbar) Beleuchtung: Durchlicht Objektivtyp: Achromatisch Abbildungsmaßstab (-fach): 20 (N.A. 0,40) achromatisch, 40 (N.A. 0,65 mit Präparatschutz) plan Stromversorgung: Netzteil, Akku Leistung: Hellfeld Einblick (°): 30° Schrägeinlblick, Kopf 360° drehbar Fokussierung: Grob- und Feintrieb (koaxial) Objekttisch: Kreuztisch Bauart: Monokular Akkubetrieben Filterhalter Leuchtfeldblende Staubschutztasche Farbe: beige-schwarz Geeignet ab 14 Jahre Leichte Gebrauchspuren Solange Vorrat reicht noch 1 Stück auf Lagermit LED-Beleuchtung und 4-fach Objektivrevolver. Solange Vorrat reicht noch 1 Stück auf Lager

Präparierbesteck in Kunststoffbox Lieferumfang: - 2 Präpariernadeln, gerade - 1 Pinzette, spitz - 1 Mikroskopier-Schere, gerade, spitz - 1 Skalpellklingenhalter - Satz von 5 Skalpellklingen Kunststoffbox, stapelbar Mikroskopische Bestecke und Skalpellklingen können einzeln nachgekauft werden!6-teilig

Zuchtset "Champignons braun", Pilze - Pilze züchten leicht gemacht - spannende Naturbeobachtung - brauner Steinchampignon - mit ausführlicher Anleitung und Arbeitsblättern und 4 Erntephasen über 3 - 4 Monate - hocharomatisches, kräftiges Aroma - für Projekte im Rahmen der Bildung für nachhaltige Entwicklung (BNE) geeignet - inklusive Online-Zugang zu digitalen Übungen Mit diesem praktischen Pilz-Zucht-Set können Sie Ihre eigenen Steinchampignons züchten. Sie werden begeistert sein, wie schnell und einfach das geht! Sie brauchen nur die Pilzbox und einen kühlen Raum (15-18 °C), zum Beispiel im Keller - sonst nichts! Für die Kinder sind solche Naturbeobachtungen faszinierend und das Aroma der frisch geernteten Steinchampignons wird alle begeistern. Ernten Sie mit Ihrer Lerngruppe bis zu vier Mal leckere Bio-Steinchampignons direkt aus Ihrer Pilz-Zucht-Box. Beobachten Sie, wie sich das Pilzgeflecht (Myzel) ausbreitet und die Pilze heranwachsen. Sie bereiten die Box vor. Nach ca. 10 Tagen hat sich das Mycel ausgebreitet. Dann geht es schnell: Die Pilze sprießen und nach weiteren 10 Tage können sie geerntet werden. Bei den ersten beiden Ernten ernten Sie i. d. R. ca. 900 g Champignons (7-10 Pilze). Projektdauer ca. 3 Wochen Lieferumfang: - 1 Pilz-Zuchtset im Karton für braune Champions - Ausführliche Anleitung -. 7 Arbeitsblätter (differenziert nach Kindergarten und Schule) - digitale Übungen zum Thema Pilze (online) - Zusätzlich benötigt: 3 Liter Wasser und ein Backofen Maße: 24 x 30 x 20 cm, Gewicht: 5 kg Video: https://youtu.be/lLg4yAF2TYIPilze züchten leicht gemacht

Lehrtafel - Das Harnsystem Hohe anatomische und medizinische Genauigkeit. Gedruckt auf hochwertigem (200g) Bilderdruckpapier. Praktisches Posterformat 50 x 67 cm Extra bestellen: Bestäbung für Lehrtafel, Schwarz, Paar (Bild und Beschreibung hierzu finden Sie am Ende der Lehrtafeln)Praktisches Posterformat von 50 x 67 cm

Insektennisthaus Für solitär lebende Insekten | DBP Mit diesem Insektennisthaus können Sie das verborgene Leben und die Entwicklungen unserer solitär lebenden Bienenarten und Schlupfwespen live erleben. Sie erhalten einen Einblick in einen bisher unbekannten Bereich. Da die Brutgänge aus durchsichtigem Material sind und die Vorderwand herausnehmbar ist, können Sie beispielsweise die Eiablage und die Larvenentwicklung bis hin zum Verschließen der Brutkammern direkt erleben. Bewohner: Hautflügler wie Wildbienen, Grab-, Falt- und Wegwespen. Aufhängeplatz: Gartenlauben, Pergolen, Mauern, Gärten und sogar Balkone bis in den dritten oder vierten Stock. Bitte hier auf regengeschützte und besonders sonnige Standorte achten! Material: Gehäuse: Holzbeton mit wetterfester Holzvorderwand. Innenleben: Durchsichtige Niströhren mit unterschiedlichen Durchmessern, speziell zur Beobachtung! Niströhren können als Ersatzartikel bei Bedarf nachbestellt werden (bitte anfragen). Größe: B 21 x H 33 x T 15 cm Gewicht: ca. 9,2 kgFür solitär lebende Insekten NEU

Ganzjahresfutter / Körnermischung - Premium Komplett-Mix Hochwertiges Ganzjahresfutter mit ölhaltigen Sonnenblumenkernen, energiereichen Erdnüssen, Hanfsamen mit viel ungesättigten Fettsäuren, echten hellen Haferflocken mit hohem Nährwert, leckeren Futterrosinen. Das Futter bietet wertvolle Mineralstoffe für Knochenbau und Eierschalenbildung. Geeignet für alle SCHWEGLER-Futtersäulen und -Silos. Zusammensetzung: Sonnenblumenkerne, Erdnüsse, Hanfsamen, Haferflocken, Futterrosinen. Vogelart: Körnerfresser + Weichfutterfresser Geeignet für Körnerfresser wie z. B. Meisen, Sperlinge, Finken und Gimpel. Diese Vögel ernähren sich von Sämereien aller Art, deren Schale sie mit dem Schnabel aufbrechen können. Außerdem geeignet für Weichfutterfresser wie z. B. Amseln, Rotkehlchen, Drosseln, Stare, Zaunkönige, Heckenbraunellen, Kleiber, Baumläufer und Spechte. Fütterungsweise: Futtersäulen, Futtersilos, Futterhäuser, Bodenfütterung. Menge: 5 kg im Plastikeimer (je nach Charge im runden oder eckigen Eimer)Ganzjahresfutter / Körnermischung NEU

Ganzjahresfutter - Futtermix schalenfrei Ganzjahresfutter / Körnermischung Dieses schalenfreie Ganzjahresfutter besteht aus naturbelassenen Rohstoffen höchster Qualität. Da es von den Vögeln restlos gefressen wird, fallen keine Rückstände am Boden an. Geeignet für alle SCHWEGLER-Futtersäulen und -Silos. Zusammensetzung: Sonnenblumenkerne, Erdnusskerne, Kanariensaat, Weizenflocken, Futterhaferflocken, Hanfsaat, Tafelöl, Futtersultaninen. Vogelart: Körnerfresser + Weichfutterfresser Geeignet für Körnerfresser wie z. B. Meisen, Sperlinge, Finken und Gimpel. Diese Vögel ernähren sich von Sämereien aller Art, deren Schale sie mit dem Schnabel aufbrechen können. Außerdem geeignet für Weichfutterfresser wie z. B. Amseln, Rotkehlchen, Drosseln, Stare, Zaunkönige, Heckenbraunellen, Kleiber, Baumläufer und Spechte. Fütterungsweise: Futtersäulen, Futtersilos, Futterhäuser, Bodenfütterung Menge: 6 kg im PlastikeimerGanzjahresfutter / Körnermischung NEU

Igelfutter Ausgewogene und vollwertige Mischung mit der Extraportion Fleisch, Insekten und Ei, angereichert mit Vitaminen, Mineralien, gut verdaulichen aufgeschlossenen Haferflocken und Sojaöl. Bestens geeignet zur Unterstützung frei lebender Igel im Sommer oder als Nahrungsangebot vor dem Winterschlaf. Inhalt: 750 gInhalt: 750 g NEU

aufsetzbarer Kreuztisch MSH-009 für Mikroskop SH-Kolleg 3431LED

Ohrmodell - 3-fach Dieses anatomische Modell zeigt detailliert den Aufbau des Ohrs und den Weg des Schalls von der Ohrmuschel bis hin zum Hörnerv. Die wichtigsten Strukturen im Mittel- und Innenohr lassen sich entnehmen, um genauer betrachtet werden zu können. Produktdetails: - Anatomisches Modell eines Ohrs - Zeigt das menschliche Ohr in 3-facher Lebensgröße - 4-teilig zerlegbar - Trommelfell mit Hammer und Amboss können vom Modell abgenommen werden - Labyrinth mit Steigbügel, Schnecke, Hör- und Gleichgewichtsnerv sind ebenfalls abnehmbar - Schnecke ist in 2 Teile zerlegbar - Handbemaltes Modell - Auf einen weißen Kunststoff-Sockel montiert - Größe (H x B x T): 20 x 36 x 15 cm Produktblatt-Ohrmodell4-teilig zerlegbar

BRESSER Dauerpräparate: Histologie 30 Dauerpräparate in Holzbox Diese Sammlung an Präparaten ermöglicht Ihnen einen perfekten Einstieg in die Mikroskopie. Es enthält 30 unterschiedliche Musterpräparate zur Histologie: 1. Lockeres Bindegewebe 2. Hyalinknorpel 3. Knorpel (elastisch) 4. Rückenmark 5. Schlüsselbein 6. Knochen (dicht) 7. Gereizter Muskel 8. Skelettmuskel 9. Sprungsehne (Kaninchen) 10. Plattenepithel Mundschleimhaut 11. Einschichtiges Ephitel 12. Drüsengewebe (geschichtet) 13. Flimmerepithel 14. Menschliche Haut, Schnitt durch Haarfollikel 15. Menschliche Haut, Schnitt durch Schweißdrüse 16. Lunge 17. Lunge mit Blutgefäßen 18. Niere mit Blutgefäßen 19. Arterie & Vene 20. Menschliches Blut (Ausstrich) 21. Lymphknoten 22. Schilddrüse 23. Magenwand 24. Dünndarm 25. Leber 26. Herzmuskel 27. Hoden 28. Eierstock 29. Niere 30. Human-Chromosom Solange Vorrat reicht noch 1 Stück auf Lager30 Dauerpräparate in Holzbox Solange Vorrat reicht noch 1 Stück auf Lager

Dauerpräparate: Tiere 30 unterschiedliche Musterpräparate zum Thema "Tiere" in Holzbox. Inhalt 1. Pantoffeltierchen 2. Pantoffeltierchen bei der Fortpflanzung (Konjugation) 3. Pantoffeltierchen bei der Teilung 4. Augentierchen 5. Süßwasserpolyp 6. Süßwasserpolyp, Eier 7. Süßwasserpolyp, längsschnitt 8. Süßwasserpolyp mit Knospe 9. Pärchenegel, männlich 10. Pärchenegel, weiblich 11. Spulwurm Eier 12. Pärchenegel, Larve im Anfangsstadium 13. Pärchenegel, fortgeschrittene Larve mit Schwanz 14. Pärchenegel bei der Fortpflanzung 15. Bandwurm 16. Bandwurm, Segmente 17. Spulwurm, männlich/weiblich 18. Spulwurm, Mitosestadien 19. Regenwurm, querschnitt 20. Honigbiene, Mundwerkzeuge 21. Stechmücke, Mundwerkzeuge 22. Stechmücke, Larve 23. Stubenfliege, Mundwerkzeuge 24. Schmetterling, Mundwerkzeuge 25. Honigbiene, Hinterbein 26. Ameise 27. Muschel, Kiemen 28. Frosch, Ei 29. Frosch, Leber, querschnitt 30. Blutausstrich, Taube Solange Vorrat reicht noch 1 Stück auf Lager30 Dauerpräparate in Holzbox Solange Vorrat reicht noch 1 Stück auf Lager

BRESSER Erudit DLX 40-1000x Mikroskop Das BRESSER Erudit DLX ist ein hervorragendes Mikroskop für Schule und Studium. Es ist mit DIN-Objektiven ausgestattet und bietet somit eine optimale Abbildungsqualität. Durchlichtmikroskop mit DIN Objektiven USB und Netzbetrieb, dadurch flexibel einsetzbar Dimmbare LED-Beleuchtung/Abbe Kondensor mit Irisblende Vergrößerung: 40x-1000x Gewicht: 2.7 kg Lieferumfang: Mikroskop, Zubehör, Netzteil Netzteil: 5V, 1A Das BRESSER Erudit DLX ist ein hochwertiges Studienmikroskop für vielfältige Einsatzmöglichkeiten, z. B. in der Schule, im Studium oder zum Hobby. Die dimmbare LED Beleuchtung des Erudit DLX und ein zentrierbarer und höhenverstellbarer Kondensor (mit Irisblende und Filterhalter) ermöglicht eine optimale Ausleuchtung. Die achromatischen DIN-Objektive sorgen für eine sehr gute Abbildung. Das 40x- und das 100x-Objektiv sind federgesichert, um Beschädigungen am Präparat zu vermeiden. Das Mikroskop besitzt einen 360° drehbaren monokularen Einblick, eine Grob- und Feinfokussierung, sowie einen koaxialen Kreuztisch mit Nonius. Eigenschaften - Typ: Biologisches Mikroskop - Einblick: Monokular - Komfortabler Einblick, 360° drehbarer Kopf - Einsatzbereiche: Biologie, Botanik, Bildung - Beleuchtung: LED, justierbarer Kondensor - Zielgruppe: Einsteiger, Fortgeschrittene - Koaxialer Kreuztisch - Integrierter Dimmer - Okular: 10x mit Zeiger - Objektive: 4x, 10x, 40x, 100x - Vergrößerung: 40x, 100x, 400x, 1000x Lieferumfang - Mikroskop - Okular 10x - 4 Objektive (4x, 10x, 40x, 100x(Öl)) - Abbe Kondensor mit Irisblende und Filterhalter - Blaufilter - Immersionsöl - Staubschutzhülle Anleitung - Erudit-DLX40-1000x, Mikroskop für Schule und Studium
